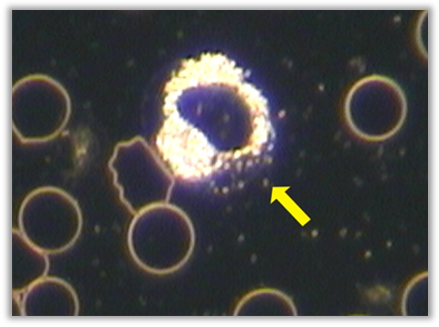
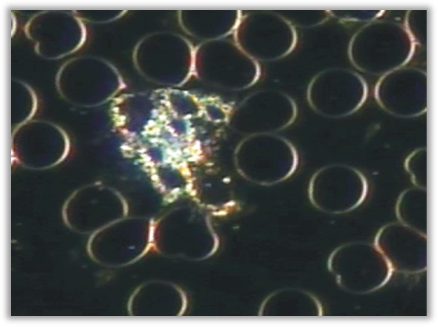
IMG_0175
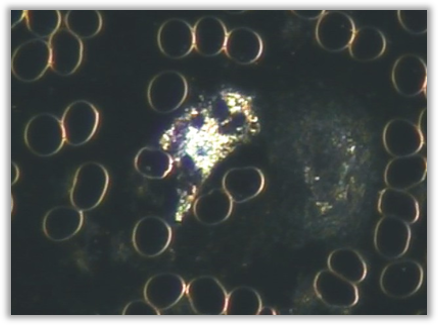
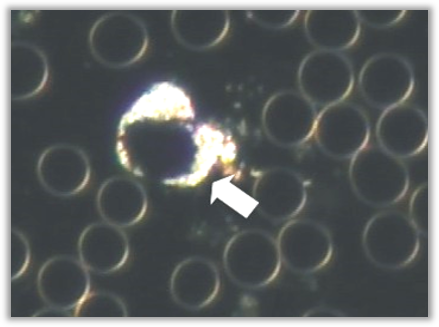
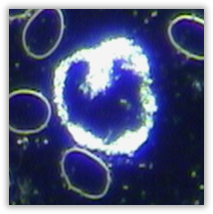
IMG_0183
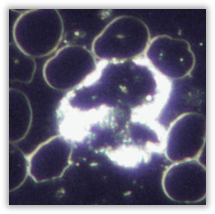
IMG_0185
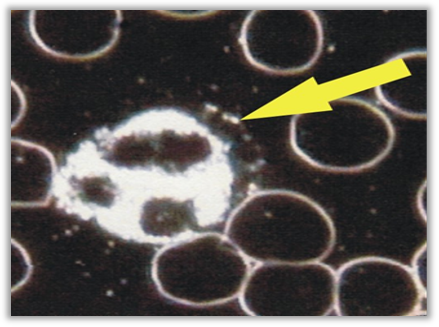
IMG_0186
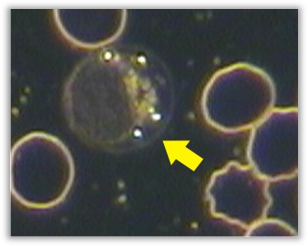
IMG_0190
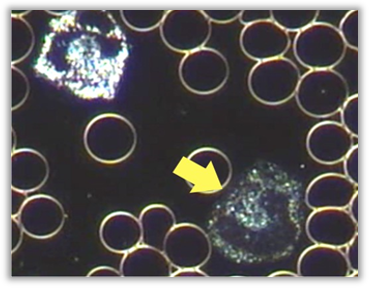
IMG_0202

Neutrophil Band Cell
Neutrophil Metamyelocyte


Neutrophil Cohesion
Hypersegmented Neutrophil

Macrocytic Meutrophil
Disrupted Neutrophil

Empty WBC

WBC With Translucent Membrane

Raised / Decreased Eosinophil Count
Raised / Decreased Basophile Count -(increased activity)
Raised / Decreased Lymphocyte Count

Lymphocyte Plasma Cells


Raised / Decreased Monocyte Count